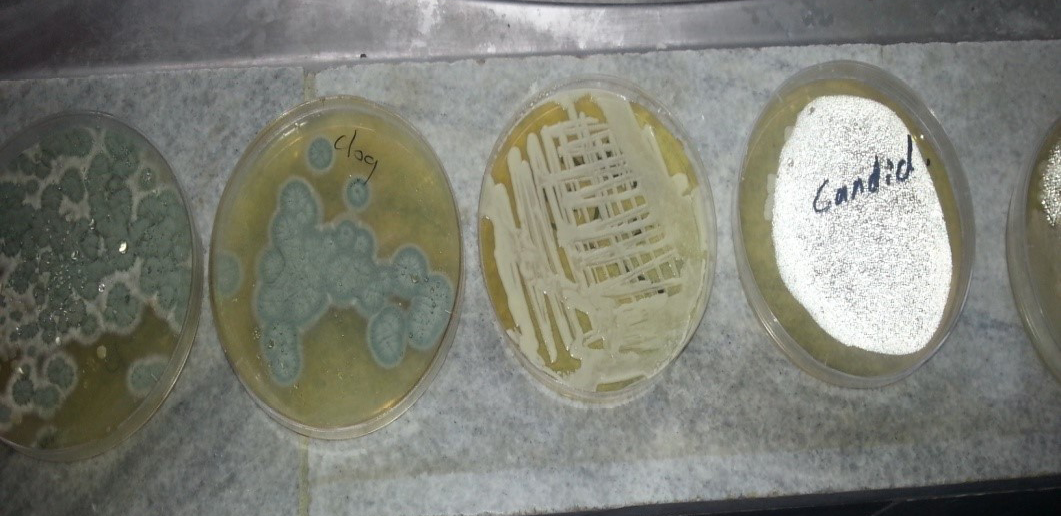
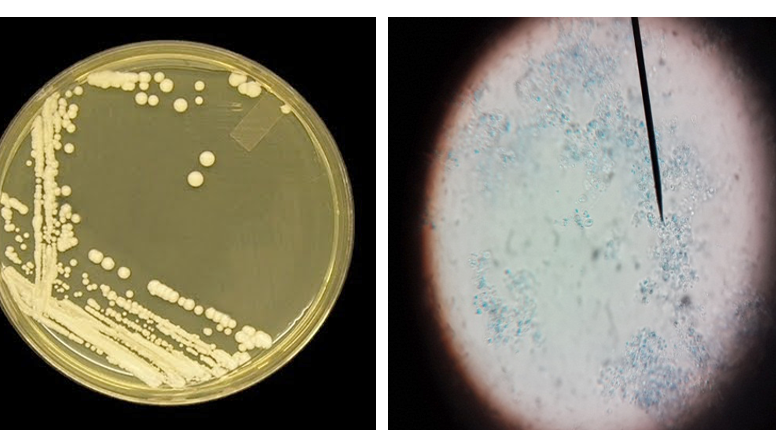
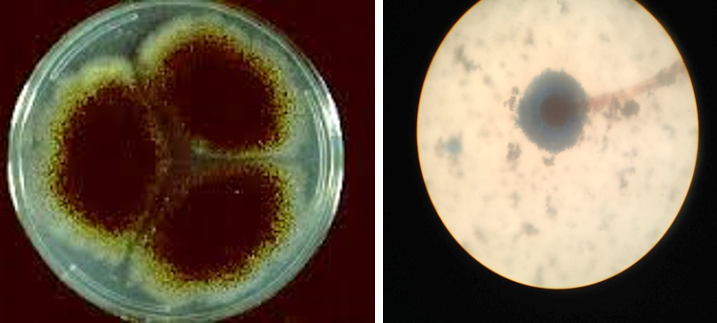
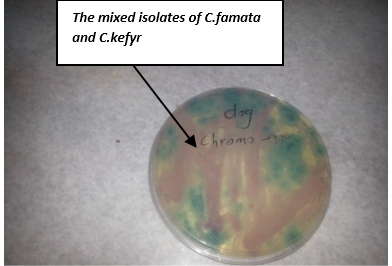

Advances in Animal and Veterinary Sciences
Different fungal culture (Yeast and Mould) isolated from O. externa in dogs
Candida colonies creamy muciod appear on SDA and Malt extract on left side and, unicellular cell of Candida stained by Lacto phenol cotton blue under X 400 on right side
A. Colonies of Penicillium on SDA; B. Penicillium spp. showing brush like arrangement of fruiting head of the conidiophores microscopically
Colony of Aspergillus niger (Black colony) on SDA, PDA from Site of infection and Aspergillus niger isolated from A
A. Aspergillus flavus colonies greenish-oily colour; B. reproductive head on Conidiophores very clear
Schematic representation of the fungal ribosomal genes containing the primer target areas used in this study
Pink to purple colour of Candida famata and Candida kefyr
Amplification profiles of the PCR products targeting the ITS1-ITS4 region
Candida kefyr lane 1, 2, 4, 5, 6, 7, 9, 10, 11 and 12: band size (722bp); Lane 3: ladder 1kb; Lane 8: negative control (TBE and loading buffer)
Amplification profiles of the PCR products targeting the ITS1-ITS4 region
Lane 1: DNA ladder 1kb; Lane 2, 3, 4, 5: Candida famata band size (633bp); Lane 6 negative control (TBE and loading buffer)